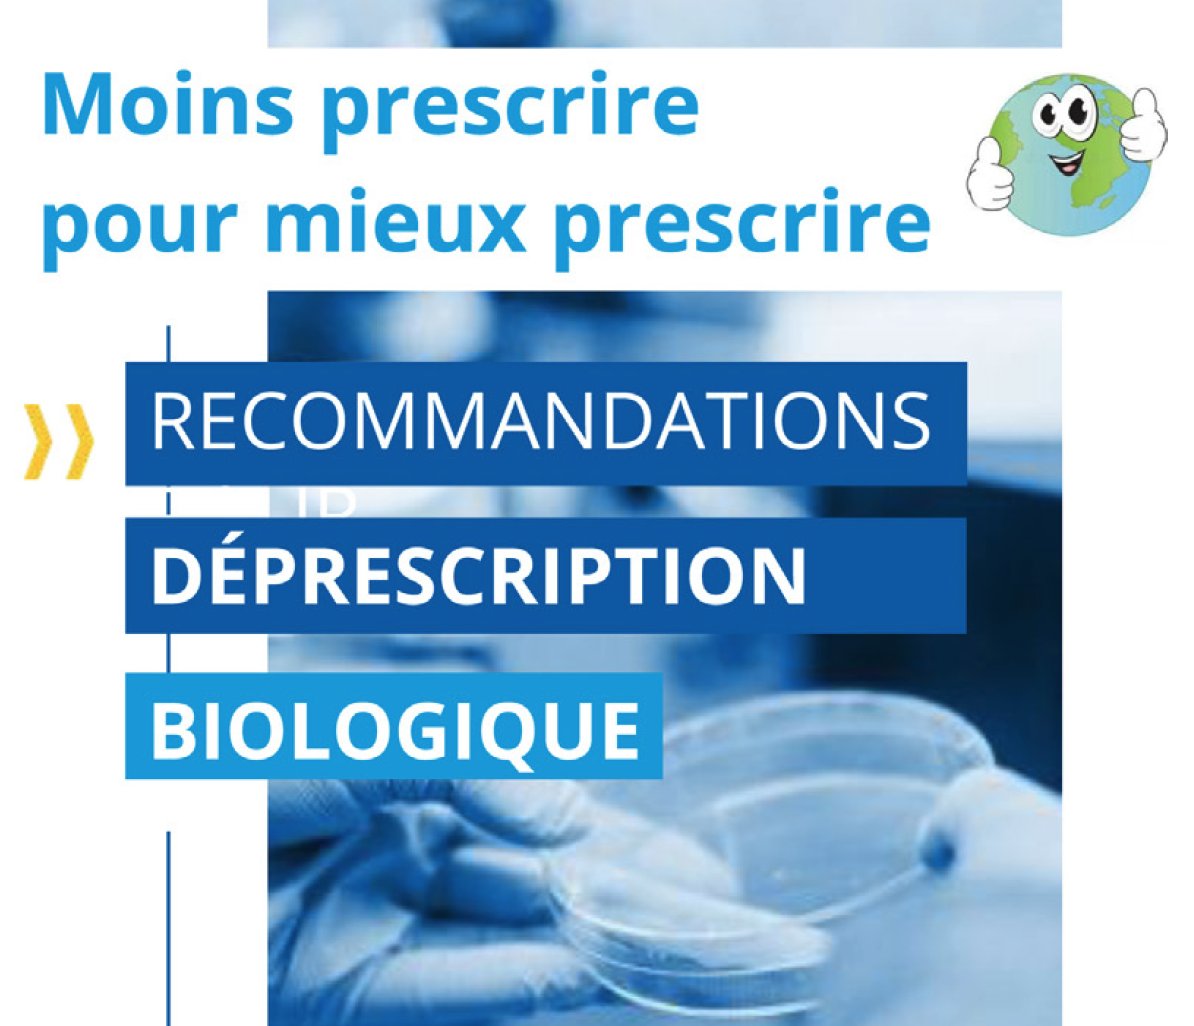
La Revue de Médecine Interne tweet media

🔔Alerte nouveau PNDS 🔔
Découvrez le PNDS sur le diagnostic et la prise en charge des péricardites récidivantes :
sciencedirect.com/science/articl…
Avec notre éditorial : "Péricardites : un nouveau paradigme ?"
sciencedirect.com/science/articl…
#PNDS #Guidelines #pericarditis #recurrent
Français